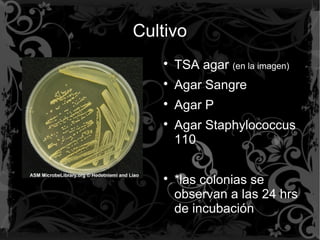
Cultivo

TSA agar (en la imagen)

Agar Sangre

Agar P

Agar Staphylococcus
110

*las colonias se
observan a las 24 hrs
de incubación

Incrustar presentación
Descargado 69 veces








Este documento describe las características de Staphylococcus spp., un cocobacilo gram positivo que se agrupa en racimos. Incluye información sobre su morfología, pruebas para identificarlo, subespecies comunes, factores de virulencia, enfermedades que causa y antibióticos a los que es susceptible.